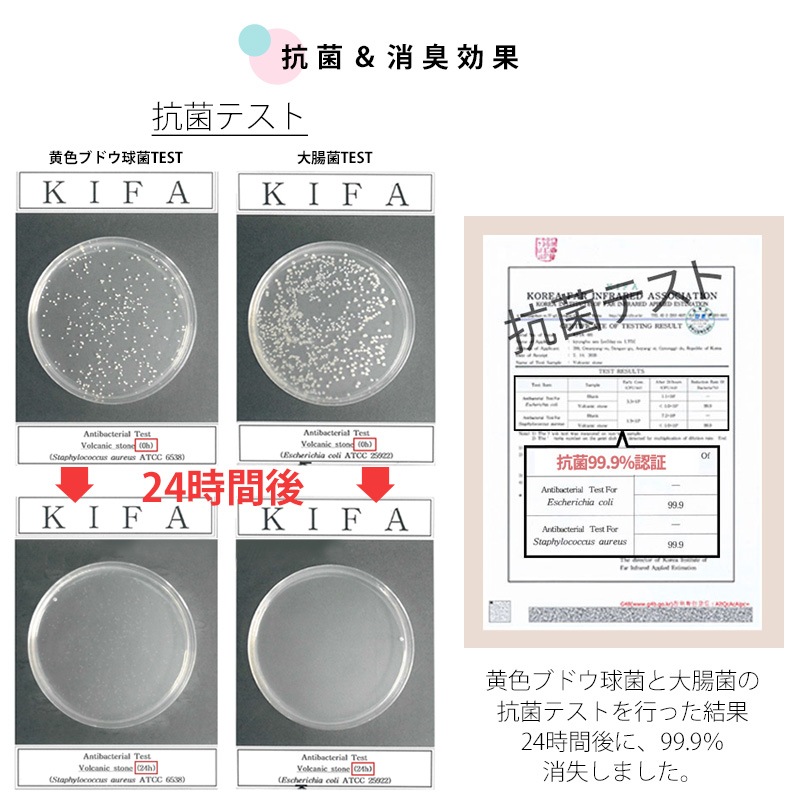

vall バル 油とりボール
¥1,650(税込)
16ポイント獲得!
- システム商品コード
- 000000002847
- 独自商品コード
- vall
- 送料について
- 6,000円以上で送料無料!
この商品についてのレビュー
レビューはまだありません

≪VALL あぶらとりボール≫
日本最大級のクラウドファンディングサービス「Makuake(マクアケ)」で大きな支持を得た”VALL あぶらとりボール”。あぶらとり紙を繰り返し使えるボール状にした韓国発の美容アイテムです。皮脂のテカリは、化粧崩れの原因となり、肌トラブルにもつながります。また、マスクの着用が日常的となり、マスクによるテカリに悩んでいる方も多いはず。そんな日常の悩みを、使うたびゴミがでる紙ではなく、何度も使用できる"ボール"形状で楽しみながら解決。消臭・抗菌テストでも結果がでているので、安心して繰り返し使用でき、汚れても簡単にクリーニングすることができます。化粧前、化粧後、マスク着用時、もちろん男性にもお使いいただける優れものです。ぜひ、その効果を体感してください!


















| サイズ | 約67×42mm |
|---|---|
| 主成分 | 火山石 |
| 重量 | 本体:(予備ボール含む)約g63、1ボールあたり:約20g |
| 付属品 | 火山石ボール×1(予備) |
| 生産国 | 韓国 |
| 使用回数 | 1ボールあたり約180回(目安:1日3回使用で約2ヶ月) |
| その他 | ぬるま湯、ウェットティッシュ、濡れタオルで洗浄可能 |